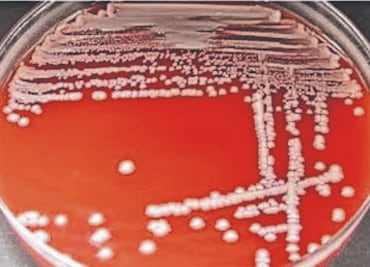
Lanzan alerta por bacteria intestinal Klebsiella oxytoca

Invierno llega con fuerza al Edomex; caída de aguanieve y bajas temperaturas sorprenden a familias en La Marquesa
El SMN Informó que las condiciones climáticas están generando lluvias, chubascos y descargas eléctricas en distintas regiones del país

El SMN Informó que las condiciones climáticas están generando lluvias, chubascos y descargas eléctricas en distintas regiones del país

Entre los arrestados se encuentran tres funcionarios municipales, tres policías y varios familiares del alcalde Pedro Luis “N”, alias “Wicho”, investigado por extorsión

Con esta estrategia, el Edomex busca que los pequeños que pasan largos periodos en tratamiento eviten el rezago y la deserción escolar, señala encargada del programa

Autoridades señalan que recibieron quejas vecinales por riñas; fueron 27 espacios asegurados por la FGJEM

Claudia Sheinbaum señaló que se pidió cancelar el contrato con SAFE por suministro de soluciones intravenosas; ayer la planta operó de manera habitual
La Secretaría de Salud federal registra 15 casos por el germen hallado en la sangre de menores

Residentes cercanos al Parque de la Ciencia dicen que estuvo más tiempo en construcción

Cuatro mandos policiales detenidos como parte del Operativo Enjambre también irán a juicio

El exdirector de Seguridad de Amanalco también fue vinculado a proceso, pero por el delito de secuestro exprés para cometer robo

El clima ha afectado los trabajos de los últimos meses; prevén destinar 200 mdp a “Bachetón”